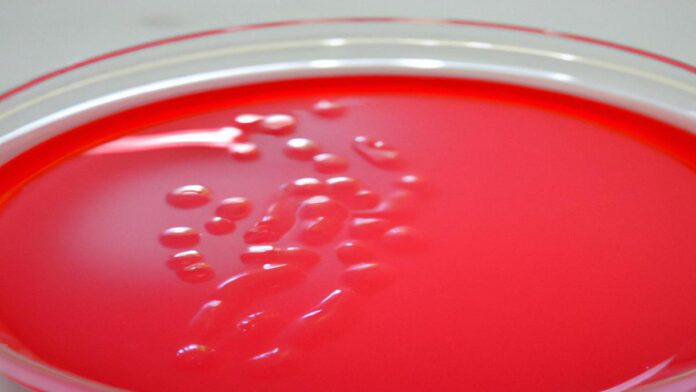

La bilirrubina es un pigmento amarillo producido por el hígado durante el normal proceso de descomposición de la hemoglobina. La bilirrubina es normalmente transportada a través de la sangre por los glóbulos rojos, que liberan hemoglobina cuando las células viejas mueren. El hígado descompone la hemoglobina inutilizada mientras se borran los productos de desecho de la sangre.
El producto de desecho resultante se llama bilirrubina.
Si una persona tiene exceso de bilirrubina, ciertas deficiencias en su hígado o en su sistema inmune pueden ser causa de esto.
La bilirrubina es un subproducto de la descomposición de las hemoglobinas.
La bilirrubina en exceso es peligrosa para el cuerpo, ya que puede acumularse en el hígado a niveles dañinos, lo que puede causar una variedad de problemas de salud. La cantidad de bilirrubina en la sangre se mide mediante una prueba de sangre llamada prueba de bilirrubina.
Una cantidad alta de bilirrubina se conoce como hiperbilirrubinemia.
Si sus niveles de bilirrubina son demasiado altos, algunos cambios pueden ayudarlo a bajar la bilirrubina. Disminución de la ingesta de alcohol: El consumo excesivo de alcohol se ha asociado con niveles elevados de bilirrubina. Esto se debe al hecho de que el hígado trabaja más duro para descomponer el alcohol, lo que a su vez aumenta la producción de bilirrubina. Dieta saludable: Una dieta saludable y equilibrada a base de frutas, verduras, granos enteros y proteínas magras puede ayudar a mejorar la salud del hígado. El hígado trabaja duro para metabolizar los alimentos, por lo que una dieta saludable le ayudará a mantener sus niveles de bilirrubina. Perder peso saludablemente: La obesidad se ha relacionado con disturbios del hígado, como la hepatitis, que pueden aumentar los niveles de bilirrubina. Trate de controlar su peso con un régimen de alimentación saludable y ejercicio regular para ayudar a reducir los niveles de bilirrubina. Tomar hierbas para el hígado y la vesícula biliar: Las hierbas, como el cardo mariano, la raíz de diente de león y el trébol, son uno de los mejores antídotos naturales para la hiperbilirrubinemia.
Estos compuestos ayudan a mejorar la función hepática, lo que contribuye a disminuir los niveles de bilirrubina. Tratamiento ayurvédico: El tratamiento ayurvédico de la hipebilirrubinemia se basa principalmente en el uso de hierbas para equilibrar las válvulas caballa-pitta-kafaya (equilibrio de vata, pitta y kafaya) del organismo. El tratamiento ayurvédico también se centra en evitar alimentos altamente tóxicos, ingerir alimentos equilibrados, reducir el estrés y la ansiedad, practicar la respiración profunda y meditación y realizar un tratamiento con hierbas para mejorar la salud del hígado.
Estilo de vida saludable: El hígado trabaja duro para descomponer la grasa no deseada y productos de desecho, por lo que una actitud saludable hacia la vida contribuirá a un funcionamiento óptimo de este órgano.
La ingestión de alcohol, fumar y tener sobrepeso no son buenas para el hígado, por lo que deben evitarse si se desea mantener los niveles de bilirrubina bajo control. Siga estos consejos y mantenga un estilo de vida saludable para reducir los niveles de bilirrubina de forma segura y natural. Si sigue teniendo niveles elevados de bilirrubina, hable con su médico para obtener un diagnóstico y tratamiento adecuados.